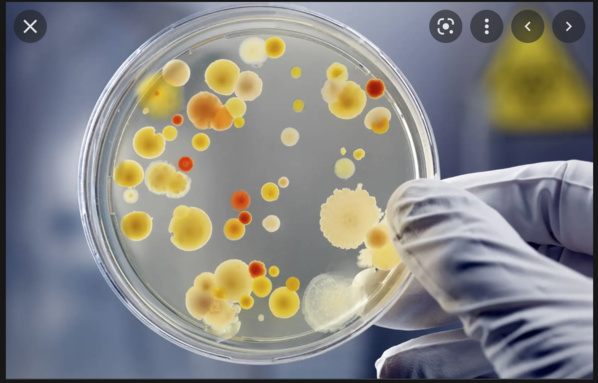
SNDE : Le changement de la qualité de l'eau à ‘’Tarhil’’ résulte de la construction d'un réservoir d'eaux usées sur le réseau de distribution SNDE : Le changement de la qualité de l'eau à ‘’Tarhil’’ résulte de la construction d'un réservoir d'eaux usées sur le réseau de distribution

La Société nationale de l’Eau (SNDE) a annoncé que l'enquête sur l'affaire de l'altération du goût et de l'odeur de l'eau, dont se plaignent certains habitants de la zone ‘’Tarhil’’ dans la moughataa de Riyad, à Nouakchott- Sud, a révélé que l'affaire est causée par une pollution consécutive à la construction d'un réservoir d'eaux usées sur l'une des canalisations du réseau d'eau par un habitant dudit quartier.
Un communiqué de la société, dont l'agence mauritanienne d’information a reçu une copie indique que : « Les services compétents de la Société nationale de l’Eau ont ouvert une enquête sur l’altération du goût et de l'odeur de l'eau dont se plaignent certains habitants du secteur 18 dans la zone de relocalisation de la moughataa de Riyad dans la wilaya de Nouakchott- Sud.
L’enquête a établi que la pollution résulte de la construction, par un habitant dudit quartier, d'un réservoir d'eaux usées sur l'une des canalisations du réseau d'eau approvisionnant le quartier.
C'est un acte choquant et préjudiciable qui met en danger la santé de son auteur et celle des membres de sa famille ainsi que de ses voisins.
La visite des lieux par les autorités administratives, communales et les responsables de l'entreprise (SNDE) a permis de prendre les mesures nécessaires, notamment écarter le danger de la pollution de la zone en cause, au demeurant limitée, étant donné qu'elle se situe à l'extrémité de l'extension géographique du réseau. Il s’est agi aussi de neutraliser le réseau affecté en vue de son remplacement.
C'est l'occasion d'appeler tous les citoyens à s’en tenir à la règlementation urbaine et à respecter l'étendue du réseau d'eau afin d'assurer la continuité du service et de préserver leur santé et celle de leurs familles et de leurs voisins.
La SNDE a commencé à assurer l'approvisionnement en eau dudit quartier grâce à des camions- citernes, en attendant le renouvellement de son réseau.
AMI
Un communiqué de la société, dont l'agence mauritanienne d’information a reçu une copie indique que : « Les services compétents de la Société nationale de l’Eau ont ouvert une enquête sur l’altération du goût et de l'odeur de l'eau dont se plaignent certains habitants du secteur 18 dans la zone de relocalisation de la moughataa de Riyad dans la wilaya de Nouakchott- Sud.
L’enquête a établi que la pollution résulte de la construction, par un habitant dudit quartier, d'un réservoir d'eaux usées sur l'une des canalisations du réseau d'eau approvisionnant le quartier.
C'est un acte choquant et préjudiciable qui met en danger la santé de son auteur et celle des membres de sa famille ainsi que de ses voisins.
La visite des lieux par les autorités administratives, communales et les responsables de l'entreprise (SNDE) a permis de prendre les mesures nécessaires, notamment écarter le danger de la pollution de la zone en cause, au demeurant limitée, étant donné qu'elle se situe à l'extrémité de l'extension géographique du réseau. Il s’est agi aussi de neutraliser le réseau affecté en vue de son remplacement.
C'est l'occasion d'appeler tous les citoyens à s’en tenir à la règlementation urbaine et à respecter l'étendue du réseau d'eau afin d'assurer la continuité du service et de préserver leur santé et celle de leurs familles et de leurs voisins.
La SNDE a commencé à assurer l'approvisionnement en eau dudit quartier grâce à des camions- citernes, en attendant le renouvellement de son réseau.
AMI

SNDE : Le changement de la qualité de l'eau à ‘’Tarhil’’ résulte de la construction d'un réservoir d'eaux usées sur le réseau de distribution